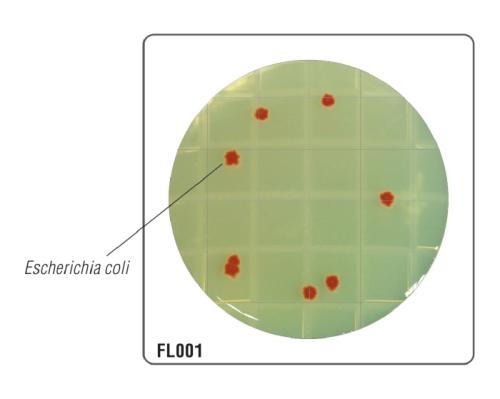
HiTouch™ Aerobic Count FlexiPlate™ для подсчета КМАФАнМ FL001

HiTouch™ Aerobic Count FlexiPlate™ для подсчета КМАФАнМ
Характеристики
Тип
Гибкие пластины с питательной средой
Упаковка
50
Общие характеристики
- Внешний вид: Стерильный формованный футляр,содержащий прозрачный или слегка опалесцирующий плотный гель светло-желтого цвета.
- Кол-во среды: 9 мл
- Реакция среды: рН 7,3 ± 0,2
- Тест на стерильность: Стерильность среды проверялась в течение 14 дней. Результат: стерильная среда без образования колоний на поверхности агара
- Реакция культуры: Характерные культуры микроорганизмов наблюдаются после инкубации при 35-37°C в течение 18-24 часов.
Запросить стоимость
Описание
- Для обнаружения и подсчета аэробных микроорганизмов
- Колонии имеют красный цвет из-за присутствия индикаторного красителя
- Температура инкубации 35 - 37oC
- Быстрый результат в течение 18-24 часов
| Организмы (ATCC) (WDCM*) | Рост | Цвет колонии |
|---|---|---|
| B. subtilis (ATCC 6633) (00003*) | активный | от красного до бордового |
| E. coli (ATCC 25922) (00013*) | активный | от красного до бордового |
| Ent. faecalis (ATCC29212) (00087*) | активный | от красного до бордового |
| S. aureus (ATCC 25923) (00034*) | активный | от красного до бордового |
| S. pyogenes (ATCC19615) | активный | от красного до бордового |
Состав:
| Ингредиент | г/л |
|---|---|
| Триптоза | 15.00 |
| Соевый пептон | 5.00 |
| Хлорид натрия | 5.00 |
| Индикатор | 0.10 |
| Агар | 15.0 |
Характеристики
Области применения
- Пищевая и молочная промышленность – проверка сырья, воздуха и поверхности;
- Птицеводство и мясная промышленность – проверка сырья, воздуха и поверхности;
- Фармацевтическая и косметическая промышленность – проверка сырья, воздуха и поверхности;
- Вода и сточные воды – лаборатории по анализу сточных вод;
- Больницы, операционные – для проверки воздуха и поверхностей в испытательных залах / I.C.U;
- Прочие производства, лаборатории, в которых проводятся работы в области микробиологии.
Документация
HiMedia Laboratories Pvt. Ltd. - абсолютный лидер по ассортименту поставляемых питательных сред.